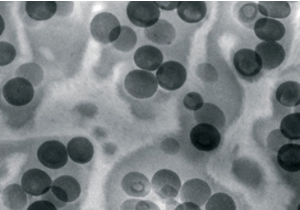
新闻图片3

上海宇北医疗器械有限公司
9 年
手机商铺
- NaN
- 0.2999999999999998
- 1.2999999999999998
- 0.2999999999999998
- 3.3
上海宇北医疗器械有限公司
入驻年限:9 年
- 联系人:
王先生
- 所在地区:
上海 闵行区
- 业务范围:
技术服务、实验室仪器 / 设备、ELISA 试剂盒、细胞库 / 细胞培养、试剂、医疗器械、体外诊断、书籍 / 软件、耗材
- 经营模式:
经销商 代理商
推荐产品
公司新闻/正文
戴通ultra sonic Maxi 钻石刀在高压冷冻线虫样品等生物样本中获得的连续切片应用
617 人阅读发布时间:2024-06-07 10:05
瑞士戴通DiATOME ultra sonic Maxi钻石刀在高压冷冻线虫样品等生物样本连续切片的应用


该超声波钻石刀具有
- 无压缩超薄切片
- 适用所有包埋树脂(环氧树脂和丙烯酸酯)
- 自动设置共振频率
- 刀角度:35°
- 由钛制成的船(内17 × 25毫米)
- 刃口容易湿润
获得专利的超声波刀可以切割超薄切片而不受压缩 (D. Studer et al., Journal of Microscopy, Vol. 197, pp. 94 – 100, 2000)。在正确设置频率和振幅的情况下,截面变得和样本的高度一样长。满意的结果不仅来自生物样品,也来自聚合物(J. S. Vastenhout et al., Microscopy and Microanalysis 8, 2001. J. S. Vastenhout et al., Microscopy Today, pp. 20 – 21, 2006)。
我们用以下样品对超声波刀进行了测试:
• Epon, Araldite, EM床等生物样品
• 丙烯酸树脂生物样品(Lowicryl, LR White)。刚性聚合物,如PS, PMMA, ABS, HIPS,改性PP,各种共混物。
用橡胶改性的聚碳酸酯 实验来自 Jens Sicking, Bayer Technology Services, Leverkusen.

超声波超薄切片 标尺1µm

用超声波Maxi刀在55nm处从高压冷冻线虫样品中获得的连续切片
实验来自 Center for Microscopy and Image Analysis, University of Zürich, Switzerland
A-用扫描电镜对硅片上收集的长带进行成像
B -系列剖面图
C -系列中的单个部分。比例尺10µm
D -蛋黄颗粒和溶酶体呈绿色。比例尺5µm;细节图:1µm
瑞士戴通ultra sonic 超声波钻石刀







